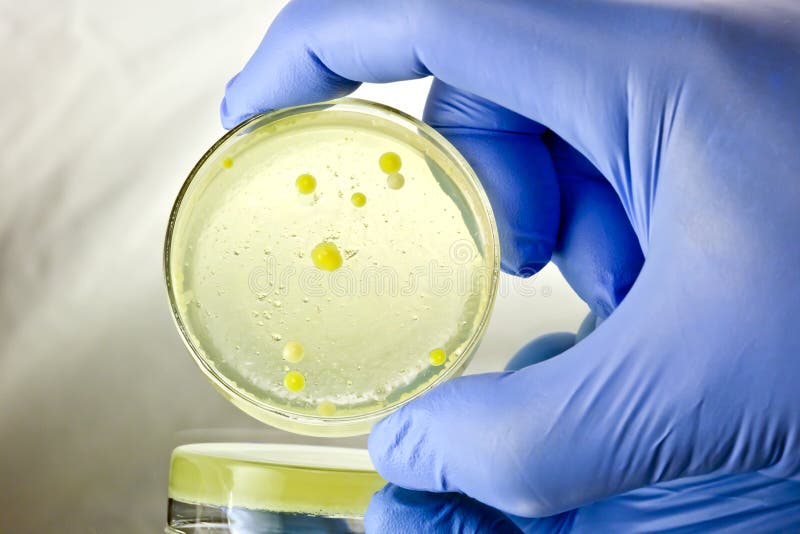
Held Petri Dish Specimen stock photography

Royalty-Free Stock Photo

Key in hand. Isolated mans hand holding a key
3
5
Exclusively on Dreamstime
- ?
$100.00USD
$240.00USD
$400.00USD
Size MAX
4368x2912px •
14.6" x 9.7" • @300dpi •
2.3MB • jpg
Author credit line
Related searches
Designers also selected these stock photos

More similar stock images
























More stock photos from Divanir4a's portfolio

























